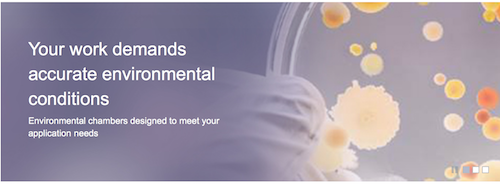

Members Login

Channels
Special Offers & Promotions
New Chambers Designed to Provide Optimum Uniformity for Stable Environmental Conditions
Thermo Scientific Environmental Chambers use a unique airflow system for advanced temperature control
A new range of 230-volt environmental chambers, designed to provide highly stable environmental conditions, is now available in Europe, Africa, Latin America and the Asia Pacific region.
The newly CE-marked range of Thermo Scientific Environmental Chambers provide temperature control above and below ambient for drug stability testing, shelf-life testing, insect studies or controlled storage. There are two models available in the range: the wide temperature units with humidity (available in 311 L and 821 L) and a heat-only model (available in 821 L) that is tailored for large-scale clinical applications and microbiology. For applications that require close control of a CO2environment, there’s an optional infrared CO2 package available that can be added to the wide temperature model.
The interior of the environmental chambers is designed for stability. The horizontal laminar airflow system enables ideal temperature uniformity and fast recovery rates, which provide an optimal growth and testing environment, even with large product loads or heat-generating equipment.
The environmental chambers feature a broad temperature range spanning from 0 to 60 degrees Celsuis and the relative humidity is easily controlled to meet the needs of different applications. Importantly, the chambers meet certain compliance and regulatory requirements, including international conference on harmonization (ICH) guidelines for drug substance and product storage testing.
“Thermo Fisher Scientific has sold environmental chambers for more than 25 years in the U.S., and we are thrilled to now introduce this product to Europe,” said Konrad Knauss, global product manager, Thermo Fisher Scientific. “Designed with the end user in mind, this series of environmental chambers is highly flexible and suited to a broad range of application needs, meaning that it fits a laboratory’s needs now as well as in the future.”
The rugged construction of the chambers promotes a long lifespan and provides a flexible and cost-effective solution for researchers. The chambers connect to standard monitoring systems for easy internal and regulatory product documentation and can be supplemented with accessories and options for many specific applications.
more about thermo fisher scientific
Media Partners